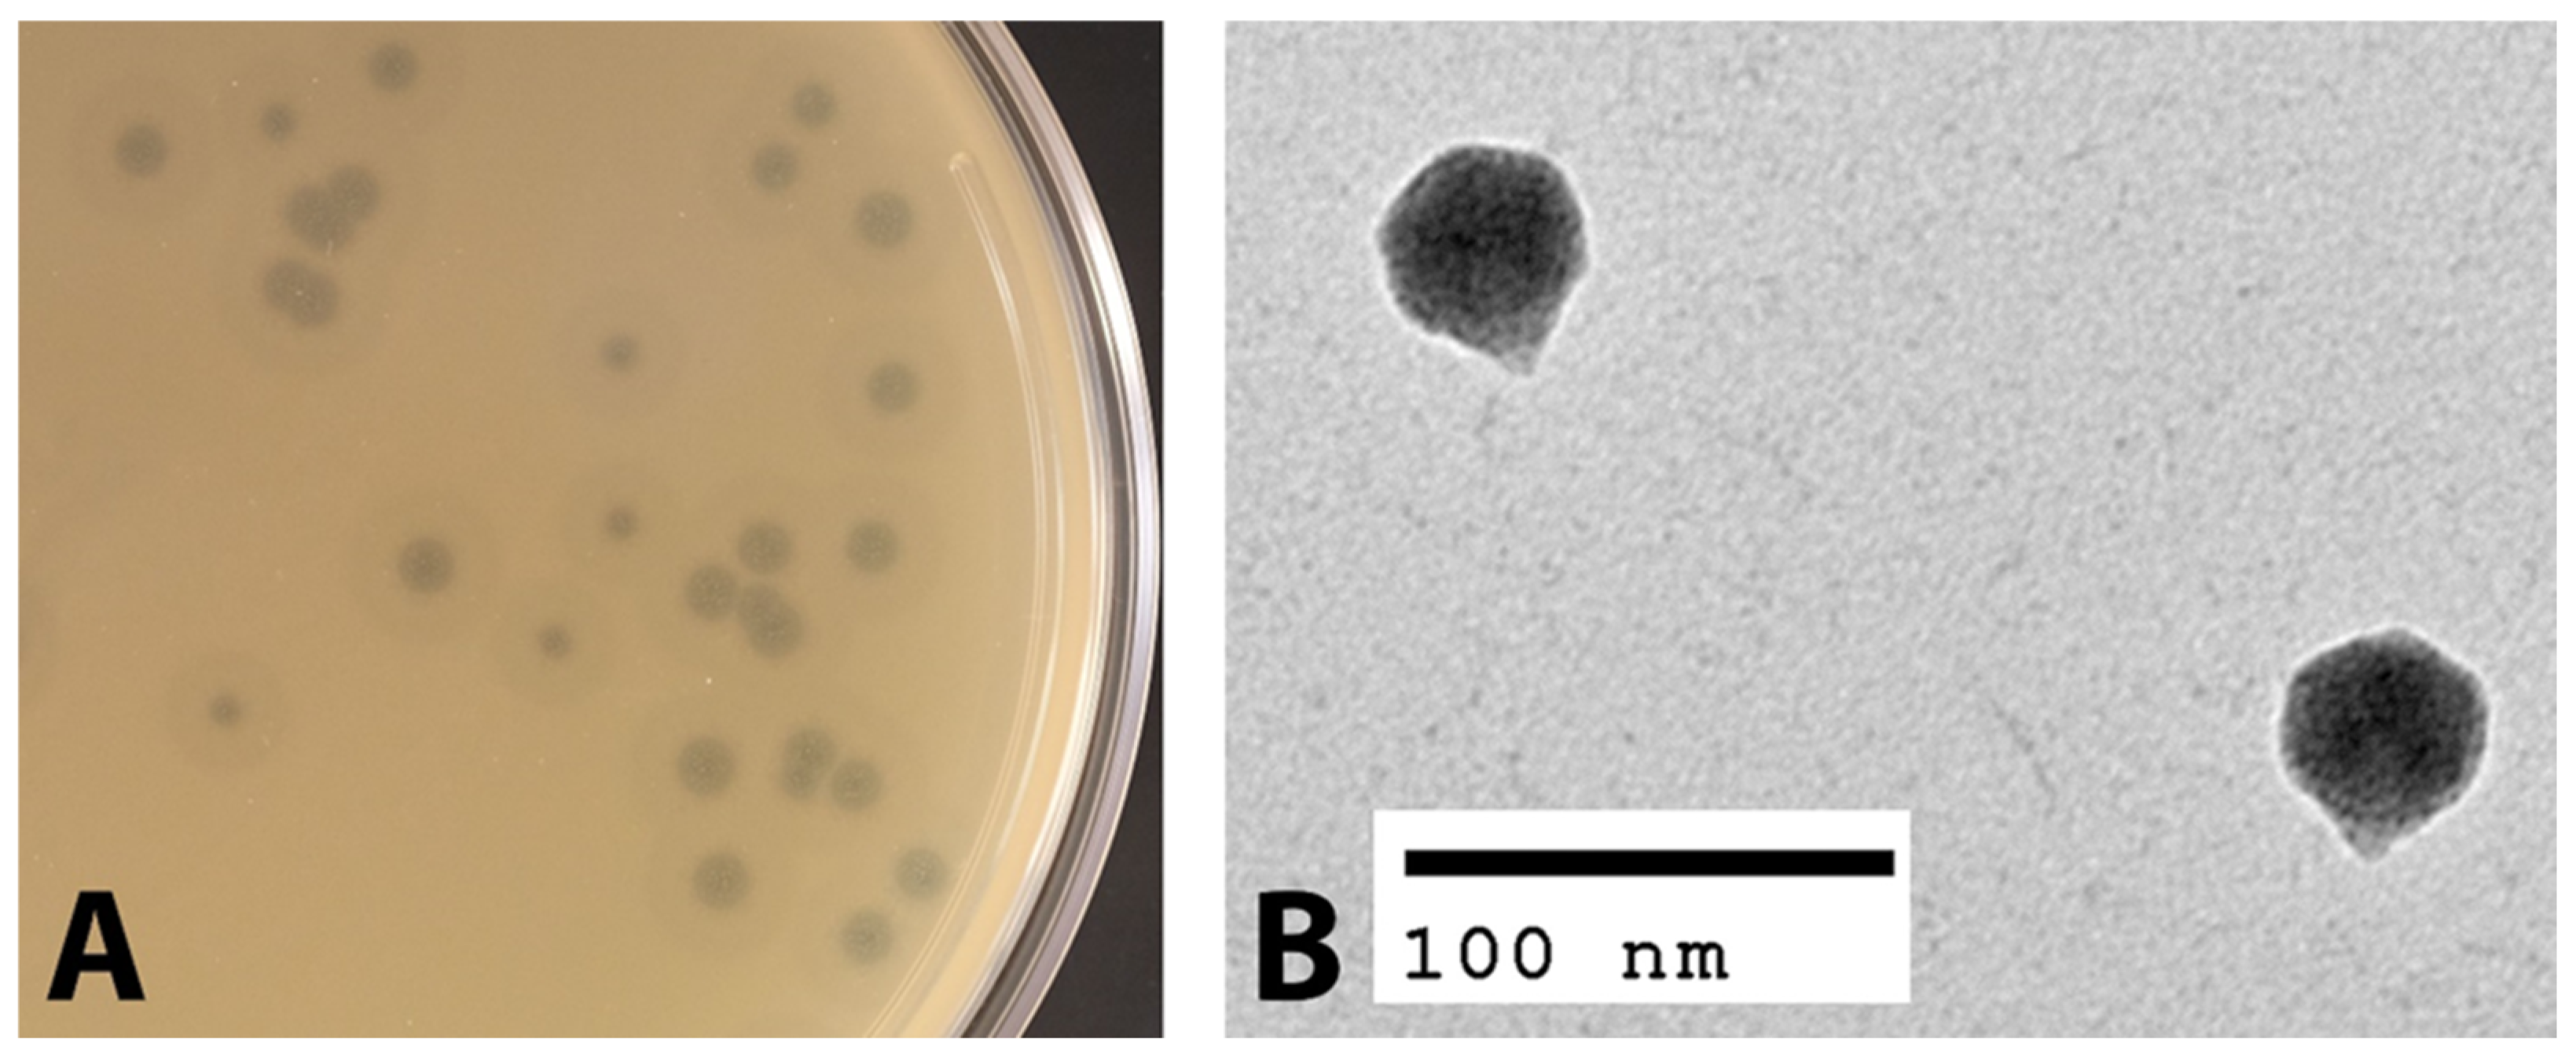
Viruses 14 00708 g001 550

Identification and Characterization of vB_PreP_EPr2, a Lytic Bacteriophage of Pan-Drug Resistant Providencia rettgeri
Abstract
:1. Introduction
2. Materials and Methods
2.1. Bacterial Strains
2.2. Phage Isolation and Propagation
2.3. Host Range Testing
2.4. Transmission Electron Microscopy
2.5. Bacterial Strains Lytic Properties Assay
2.6. Determination of Optimal Multiplicity of Infection
2.7. One Step Growth Curve
2.8. DNA Extraction and Whole Genome Sequencing
3. Results
3.1. Morphological Characterization of EPr2
3.2. Host Range of EPr2
3.3. Lytic Properties of EPr2
3.4. Genomic Analysis of EPr2
4. Discussion
Supplementary Materials
Author Contributions
Funding
Institutional Review Board Statement
Informed Consent Statement
Data Availability Statement
Acknowledgments
Conflicts of Interest
References
- Nordmann, P.; Naas, T.; Poirel, L. Global spread of carbapenemase-producing Enterobacteriaceae. Emerg. Infect. Dis. 2011, 17, 1791–1798. [Google Scholar] [CrossRef] [PubMed]
- O’Hara, C.M.; Brenner, F.W.; Miller, J.M. Classification, identification, and clinical significance of Proteus, Providencia, and Morganella. Clin. Microbiol. Rev. 2000, 13, 534–546. [Google Scholar] [CrossRef] [PubMed]
- Wie, S.H. Clinical significance of Providencia bacteremia or bacteriuria. Korean J. Intern. Med. 2015, 30, 167–169. [Google Scholar] [CrossRef] [PubMed]
- Yoh, M.; Matsuyama, J.; Ohnishi, M.; Takagi, K.; Miyagi, H.; Mori, K.; Park, K.S.; Ono, T.; Honda, T. Importance of Providencia species as a major cause of travellers’ diarrhoea. J. Med. Microbiol. 2005, 54 Pt 11, 1077–1082. [Google Scholar] [CrossRef]
- Abdallah, M.; Balshi, A. First literature review of carbapenem-resistant Providencia. New Microbes New Infect. 2018, 25, 16–23. [Google Scholar] [CrossRef]
- Iwata, S.; Tada, T.; Hishinuma, T.; Tohya, M.; Oshiro, S.; Kuwahara-Arai, K.; Ogawa, M.; Shimojima, M.; Kirikae, T. Emergence of carbapenem-resistant Providencia rettgeri and Providencia stuartii producing IMP-Type Metallo-beta-Lactamase in Japan. Antimicrob. Agents Chemother. 2020, 64, e00382-20. [Google Scholar] [CrossRef]
- Shin, S.; Jeong, S.H.; Lee, H.; Hong, J.S.; Park, M.J.; Song, W. Emergence of multidrug-resistant Providencia rettgeri isolates co-producing NDM-1 carbapenemase and PER-1 extended-spectrum beta-lactamase causing a first outbreak in Korea. Ann. Clin. Microbiol. Antimicrob. 2018, 17, 20. [Google Scholar] [CrossRef]
- Piza-Buitrago, A.; Rincon, V.; Donato, J.; Saavedra, S.Y.; Duarte, C.; Morero, J.; Falquet, L.; Reguero, M.T.; Barreto-Hernandez, E. Genome-based characterization of two Colombian clinical Providencia rettgeri isolates co-harboring NDM-1, VIM-2, and other beta-lactamases. BMC Microbiol. 2020, 20, 345. [Google Scholar] [CrossRef]
- Mc Gann, P.; Geringer, M.R.; Hall, L.R.; Lebreton, F.; Markelz, E.; Kwak, Y.I.; Johnson, S.; Ong, A.C.; Powell, A.; Tekle, T.; et al. Pan-drug resistant Providencia rettgeri contributing to a fatal case of COVID-19. J. Med. Microbiol. 2021, 70, 001406. [Google Scholar] [CrossRef]
- Patel, N.B.; Jain, G.; Chandrakar, S.; Walikar, B.N. Ventilator-associated pneumonia due to carbapenem-resistant Providencia rettgeri. BMJ Case Rep. 2021, 14, e243908. [Google Scholar] [CrossRef]
- Chegini, Z.; Khoshbayan, A.; Vesal, S.; Moradabadi, A.; Hashemi, A.; Shariati, A. Bacteriophage therapy for inhibition of multi drug-resistant uropathogenic bacteria: A narrative review. Ann. Clin. Microbiol. Antimicrob. 2021, 20, 30. [Google Scholar] [CrossRef] [PubMed]
- Kakasis, A.; Panitsa, G. Bacteriophage therapy as an alternative treatment for human infections. A comprehensive review. Int. J. Antimicrob. Agents 2019, 53, 16–21. [Google Scholar] [CrossRef]
- Oliveira, H.; Pinto, G.; Mendes, B.; Dias, O.; Hendrix, H.; Akturk, E.; Noben, J.P.; Gawor, J.; Łobocka, M.; Lavigne, R.; et al. A tailspike with exopolysaccharide depolymerase activity from a new Providencia stuartii phage makes multidrug-resistant bacteria susceptible to serum-mediated killing. Appl. Environ. Microbiol. 2020, 86, e00073-20. [Google Scholar] [CrossRef] [PubMed]
- Mangalea, M.R.; Duerkop, B.A. Fitness trade-offs resulting from bacteriophage resistance potentiate synergistic antibacterial strategies. Infect. Immun. 2020, 88, e00926-19. [Google Scholar] [CrossRef] [PubMed] [Green Version]
- Li, M.; Li, P.; Chen, L.; Guo, G.; Xiao, Y.; Chen, L.; Du, H.; Zhang, W. Identification of a phage-derived depolymerase specific for KL64 capsule of Klebsiella pneumoniae and its anti-biofilm effect. Virus Genes 2021, 57, 434–442. [Google Scholar] [CrossRef]
- Canfield, G.S.; Catterjee, A.; Espinosa, J.; Mangalea, M.R.; Sheriff, E.K.; Keidan, M.; McBride, S.W.; McCollister, B.D.; Hang, H.C.; Buerkop, B.A. Lytic bacteriophages facilitate antibiotic sensitization of Enterococcus faecium. Antimicrob. Agents Chemother. 2021, 65, e00143-21. [Google Scholar] [CrossRef]
- Engeman, E.; Freyberger, H.R.; Corey, B.W.; Ward, A.M.; He, Y.; Nikolich, M.P.; Filippov, A.A.; Tyner, S.D.; Jacobs, A.C. Synergistic killing and re-sensitization of Pseudomonas aeruginosa to antibiotics by phage-antibiotic combination treatment. Pharmaceuticals 2021, 14, 184. [Google Scholar] [CrossRef]
- Oliveira, H.; Pinto, G.; Hendrix, H.; Noben, J.P.; Gawor, J.; Kropinski, A.M.; Łobocka, M.; Lavigne, R.; Azeredo, J. A lytic Providencia rettgeri virus of potential therapeutic value is a deep-branching member of the T5 virus genus. Appl. Environ. Microbiol. 2017, 83, e01567-17. [Google Scholar] [CrossRef] [Green Version]
- Rakov, C.; Ben Porat, S.; Alkalay-Oren, S.; Yerushalmy, O.; Abdalrhman, M.; Gronovich, N.; Huang, L.; Pride, D.; Coppenhagen-Glazer, S.; Nir-Paz, R.; et al. Targeting biofilm of MDR Providencia stuartii by phages using a catheter model. Antibiotics 2021, 10, 375. [Google Scholar] [CrossRef]
- Sambrook, J.; Fritsch, E.F.; Maniatis, T. Molecular Cloning: A Laboratory Manual, 2nd ed.; Cold Spring Harbor Laboratory Press: Cold Spring Harbor, NY, USA, 1989. [Google Scholar]
- Sergueev, K.V.; Filippov, A.A.; Farlow, J.; Su, W.; Kvachadze, L.; Balarjishvili, N.; Kutateladze, M.; Nikolich, M.P. Correlation of host range expansion of therapeutic bacteriophage Sb-1 with allele state at a hypervariable repeat locus. Appl. Environ. Microbiol. 2019, 85, e0109-19. [Google Scholar] [CrossRef] [Green Version]
- Ackermann, H.W. Basic phage electron microscopy. Methods Mol. Biol. 2009, 501, 113–126. [Google Scholar]
- Sergueev, K.V.; He, Y.; Borschel, R.H.; Nikolich, M.P.; Filippov, A.A. Rapid and sensitive detection of Yersinia pestis using amplification of plague diagnostic bacteriophages monitored by real-time PCR. PLoS ONE 2010, 5, e11337. [Google Scholar] [CrossRef] [PubMed] [Green Version]
- Song, M.; Wu, D.; Hu, Y.; Luo, H.; Li, G. Characterization of an Enterococcus faecalis bacteriophage vB_EfaM_LG1 and its synergistic effect with antibiotic. Front. Cell Infect. Microbiol. 2021, 11, 698807. [Google Scholar] [CrossRef] [PubMed]
- Kropinski, A.M. Practical advice on the one-step growth curve. Methods Mol. Biol. 2018, 168, 41–47. [Google Scholar]
- Jakočiūnė, D.; Moodley, A. A rapid bacteriophage DNA extraction method. Methods Protoc. 2018, 1, 27. [Google Scholar] [CrossRef] [PubMed] [Green Version]
- Wick, R.R.; Judd, L.M.; Gorrie, C.L.; Holt, K.E. Unicycler: Resolving bacterial genome assemblies from short and long sequencing reads. PLoS Comput. Biol. 2017, 13, e1005595. [Google Scholar] [CrossRef] [Green Version]
- Garneau, J.R.; Depardieu, F.; Fortier, L.C.; Bikard, D.; Monot, M. PhageTerm: A tool for fast and accurate determination of phage termini and packaging mechanism using next-generation sequencing data. Sci. Rep. 2017, 7, 8292. [Google Scholar] [CrossRef]
- Hyatt, D.; Chen, G.; Locascio, P.F.; Land, M.L.; Larimer, F.W.; Hauser, L.J. Prodigal: Prokaryotic gene recognition and translation initiation site identification. BMC Bioinform. 2010, 11, 119. [Google Scholar] [CrossRef] [Green Version]
- Ondov, B.D.; Treangen, T.J.; Melsted, P.; Mallonee, A.B.; Bergman, N.H.; Koren, S.; Phillippy, A.M. Mash: Fast genome and metagenome distance estimation using MinHash. Genome Biol. 2016, 17, 132. [Google Scholar] [CrossRef] [Green Version]
- Clarke, T.H.; Brinkac, L.M.; Sutton, G.; Fouts, D.E. GGRaSP: A R-package for selecting representative genomes using Gaussian mixture models. Bioinformatics 2018, 34, 3032–3034. [Google Scholar] [CrossRef]
- Harper, D.R.; Parracho, H.; Walker, J.; Sharp, R.; Hughes, G.; Werthen, M.; Lehman, S.; Morales, S. Bacteriophages and biofilms. Antibiotics 2014, 3, 270–284. [Google Scholar] [CrossRef]
- Bolger, A.M.; Lohse, M.; Usadel, B. Trimmomatic: A flexible trimmer for Illumina sequence data. Bioinformatics 2014, 30, 2114–2120. [Google Scholar] [CrossRef] [PubMed] [Green Version]
- Ilie, L.; Molnar, M. RACER: Rapid and accurate correction of errors in reads. Bioinformatics 2013, 29, 2490–2493. [Google Scholar] [CrossRef] [PubMed] [Green Version]
- Wood, D.E.; Lu, J.; Langmead, B. Improved metagenomic analysis with Kraken 2. Genome Biol. 2019, 20, 257. [Google Scholar] [CrossRef] [Green Version]
- Kim, D.; Paggi, J.M.; Park, C.; Bennett, C.; Salzberg, S.L. Graph-based genome alignment and genotyping with HISAT2 and HISAT-genotype. Nat. Biotechnol. 2019, 37, 907–915. [Google Scholar] [CrossRef]
- Lefkowitz, E.J.; Dempsey, D.M.; Hendrickson, R.C.; Orton, R.J.; Siddell, S.G.; Smith, D.B. Virus taxonomy: The database of the International Committee on Taxonomy of Viruses (ICTV). Nucleic Acids Res. 2018, 46, D708–D717. [Google Scholar] [CrossRef] [Green Version]
- Bankevich, A.; Nurk, S.; Antipov, D.; Gurevich, A.A.; Dvorkin, M.; Kulikov, A.S.; Lesin, V.M.; Nikolenko, S.I.; Pham, S.; Prjibelski, A.D.; et al. SPAdes: A new genome assembly algorithm and its applications to single-cell sequencing. J. Comput. Biol. 2012, 19, 455–477. [Google Scholar] [CrossRef] [Green Version]
- Pearson, W.R. Finding protein and nucleotide similarities with FASTA. Curr. Protoc. Bioinform. 2016, 53, 3.9.1–3.9.25. [Google Scholar] [CrossRef]
- Lueder, M.R.; Cer, R.Z.; Patrick, M.; Voegtly, L.J.; Long, K.A.; Rice, G.K.; Bishop-Lilly, K.A. Manual Annotation Studio (MAS): A collaborative platform for manual functional annotation of viral and microbial genomes. BMC Genom. 2021, 22, 733. [Google Scholar] [CrossRef]
- Seemann, T. Prokka: Rapid prokaryotic genome annotation. Bioinformatics 2014, 30, 2068–2069. [Google Scholar] [CrossRef]
- Delcher, A.L.; Bratke, K.A.; Powers, E.C.; Salzberg, S.L. Identifying bacterial genes and endosymbiont DNA with Glimmer. Bioinformatics 2007, 23, 673–679. [Google Scholar] [CrossRef] [PubMed]
- McNair, K.; Zhou, C.; Dinsdale, E.A.; Souza, B.; Edwards, R.A. PHANOTATE: A novel approach to gene identification in phage genomes. Bioinformatics 2019, 35, 4537–4542. [Google Scholar] [CrossRef] [PubMed] [Green Version]
- Marcais, G.; Kingsford, C. A fast, lock-free approach for efficient parallel counting of occurrences of k-mers. Bioinformatics 2011, 27, 764–770. [Google Scholar] [CrossRef] [PubMed] [Green Version]
- Laslett, D.; Canback, B. ARAGORN, a program to detect tRNA genes and tmRNA genes in nucleotide sequences. Nucleic Acids Res. 2004, 32, 11–16. [Google Scholar] [CrossRef]
- Chan, P.P.; Lowe, T.M. tRNAscan-SE: Searching for tRNA genes in genomic sequences. Methods Mol. Biol. 2019, 1962, 1–14. [Google Scholar]
- Bryant, D.M.; Johnson, K.; DiTommaso, T.; Tickle, T.; Couger, M.B.; Payzin-Dogru, D.; Lee, T.J.; Leigh, N.D.; Kuo, T.H.; Davis, F.G.; et al. A tissue-mapped axolotl transcriptome enables identification of limb regeneration factors. Cell Rep. 2017, 18, 762–776. [Google Scholar] [CrossRef] [Green Version]
- Feldgarden, M.; Brover, V.; Haft, D.H.; Prasad, A.B.; Slotta, D.J.; Tolstoy, I.; Tyson, G.H.; Zhao, S.; Hsu, C.H.; McDermott, P.F.; et al. Validating the AMRFinder Tool and Resistance Gene Database by Using Antimicrobial Resistance Genotype-Phenotype Correlations in a Collection of Isolates. Antimicrob. Agents Chemother. 2019, 63, e00483-19. [Google Scholar] [CrossRef] [Green Version]
- Jia, B.; Raphenya, A.R.; Alcock, B.; Waglechner, N.; Guo, P.; Tsang, K.K.; Lago, B.A.; Dave, B.M.; Pereira, S.; Sharma, A.N.; et al. CARD 2017: Expansion and model-centric curation of the comprehensive antibiotic resistance database. Nucleic Acids Res. 2017, 45, D566–D573. [Google Scholar] [CrossRef]
- Zankari, E.; Hasman, H.; Cosentino, S.; Vestergaard, M.; Rasmussen, S.; Lund, O.; Aarestrup, F.M.; Larsen, M.V. Identification of acquired antimicrobial resistance genes. J. Antimicrob. Chemother. 2012, 67, 2640–2644. [Google Scholar] [CrossRef]
- Gupta, S.K.; Padmanabhan, B.R.; Diene, S.M.; Lopez-Rojas, R.; Kempf, M.; Landraud, L.; Rolain, J.M. ARG-ANNOT, a new bioinformatic tool to discover antibiotic resistance genes in bacterial genomes. Antimicrob. Agents Chemother. 2014, 58, 212–220. [Google Scholar] [CrossRef] [Green Version]
- Chen, L.; Zheng, D.; Liu, B.; Yang, J.; Jin, Q. VFDB 2016: Hierarchical and refined dataset for big data analysis—10 years on. Nucleic Acids Res. 2016, 44, D694–D697. [Google Scholar] [CrossRef] [PubMed]
- Carattoli, A.; Zankari, E.; Garcia-Fernandez, A.; Voldby Larsen, M.; Lund, O.; Villa, L.; Moller Aarestrup, F.; Hasman, H. In silico detection and typing of plasmids using PlasmidFinder and plasmid multilocus sequence typing. Antimicrob. Agents Chemother. 2014, 58, 3895–3903. [Google Scholar] [CrossRef] [Green Version]
- Ingle, D.J.; Valcanis, M.; Kuzevski, A.; Tauschek, M.; Inouye, M.; Stinear, T.P.; Levine, M.M.; Robins-Browne, R.M.; Holt, K.E. In silico serotyping of E. coli from short read data identifies limited novel O-loci but extensive diversity of O:H serotype combinations within and between pathogenic lineages. Microb. Genom. 2016, 2, e000064. [Google Scholar] [CrossRef] [PubMed]
- Doster, E.; Lakin, S.M.; Dean, C.J.; Wolfe, C.; Young, J.G.; Boucher, C.; Belk, K.E.; Noyes, N.R.; Morley, P.S. MEGARes 2.0: A database for classification of antimicrobial drug, biocide and metal resistance determinants in metagenomic sequence data. Nucleic Acids Res. 2020, 48, D561–D569. [Google Scholar] [CrossRef]
- Zhou, C.E.; Smith, J.; Lam, M.; Zemla, A.; Dyer, M.D.; Slezak, T. MvirDB—A microbial database of protein toxins, virulence factors and antibiotic resistance genes for bio-defence applications. Nucleic Acids Res. 2007, 35, D391–D394. [Google Scholar] [CrossRef] [PubMed]
- Chakraborty, A.; Ghosh, S.; Chowdhary, G.; Maulik, U.; Chakrabarti, S. DBETH: A database of bacterial exotoxins for human. Nucleic Acids Res. 2012, 40, D615–D620. [Google Scholar] [CrossRef] [PubMed]
- Jones, P.; Binns, D.; Chang, H.Y.; Fraser, M.; Li, W.; McAnulla, C.; McWilliam, H.; Maslen, J.; Mitchell, A.; Nuka, G.; et al. InterProScan 5: Genome-scale protein function classification. Bioinformatics 2014, 30, 1236–1240. [Google Scholar] [CrossRef] [Green Version]
- Stothard, P.; Wishart, D.S. Circular genome visualization and exploration using CGView. Bioinformatics 2005, 21, 537–539. [Google Scholar] [CrossRef] [Green Version]
- Lorenz, R.; Bernhart, S.H.; Höner zu Siederdissen, C.; Tafer, H.; Flamm, C.; Stadler, P.F.; Hofacker, I.L. ViennaRNA Package 2.0. Algorithms Mol. Biol. 2011, 6, 26. [Google Scholar] [CrossRef]
- Duan, Y.; Llorente, C.; Lang, S.; Brandl, K.; Chu, H.; Jiang, L.; White, R.C.; Clarke, T.H.; Nguyen, K.; Torralba, M.; et al. Bacteriophage targeting of gut bacterium attenuates alcoholic liver disease. Nature 2019, 575, 505–511. [Google Scholar] [CrossRef]
- Paradis, E.; Schliep, K. ape 5.0: An environment for modern phylogenetics and evolutionary analyses in R. Bioinformatics 2019, 35, 526–528. [Google Scholar] [CrossRef] [PubMed]
- Letunic, I.; Bork, P. Interactive tree of life (iTOL) v3: An online tool for the display and annotation of phylogenetic and other trees. Nucleic Acids Res. 2016, 44, W242–W245. [Google Scholar] [CrossRef] [PubMed]

| P. rettgeri Strain ID | Collection Date | Isolate Source | EPr2 Sensitivity 3 |
|---|---|---|---|
| MRSN 12965 | 4 December 2012 | Surveillance | − |
| MRSN 21225 | 3 March 2014 | Respiratory | − |
| MRSN 26563 | 13 October 2014 | Urine | − |
| MRSN 31245 | 23 July 2015 | Stool | − |
| MRSN 32788 | 10 August 2015 | Stool | − |
| MRSN 33475 | 24 August 2015 | Wound | − |
| MRSN 386496 | 22 April 2016 | Urine | − |
| MRSN 768611 | 26 March 2020 | Urine | − |
| MRSN 845308 1,2 | 1 November 2020 | Blood | + |
| MRSN 849144 2 | 6 November 2020 | Surveillance | + |
| MRSN 849312 2 | 9 November 2020 | Blood | + |
| MRSN 877360 | 25 December 2020 | Urine | − |
| MRSN 883526 | 24 February 2021 | Surveillance | − |
| ATCC 29944 | N/A 4 | N/A | − |
Publisher’s Note: MDPI stays neutral with regard to jurisdictional claims in published maps and institutional affiliations. |
© 2022 by the authors. Licensee MDPI, Basel, Switzerland. This article is an open access article distributed under the terms and conditions of the Creative Commons Attribution (CC BY) license (https://creativecommons.org/licenses/by/4.0/).
Share and Cite
Mencke, J.L.; He, Y.; Filippov, A.A.; Nikolich, M.P.; Belew, A.T.; Fouts, D.E.; McGann, P.T.; Swierczewski, B.E.; Getnet, D.; Ellison, D.W.; et al. Identification and Characterization of vB_PreP_EPr2, a Lytic Bacteriophage of Pan-Drug Resistant Providencia rettgeri. Viruses 2022, 14, 708. https://doi.org/10.3390/v14040708
Mencke JL, He Y, Filippov AA, Nikolich MP, Belew AT, Fouts DE, McGann PT, Swierczewski BE, Getnet D, Ellison DW, et al. Identification and Characterization of vB_PreP_EPr2, a Lytic Bacteriophage of Pan-Drug Resistant Providencia rettgeri. Viruses. 2022; 14(4):708. https://doi.org/10.3390/v14040708
Chicago/Turabian StyleMencke, Jaime L., Yunxiu He, Andrey A. Filippov, Mikeljon P. Nikolich, Ashton T. Belew, Derrick E. Fouts, Patrick T. McGann, Brett E. Swierczewski, Derese Getnet, Damon W. Ellison, and et al. 2022. "Identification and Characterization of vB_PreP_EPr2, a Lytic Bacteriophage of Pan-Drug Resistant Providencia rettgeri" Viruses 14, no. 4: 708. https://doi.org/10.3390/v14040708
APA StyleMencke, J. L., He, Y., Filippov, A. A., Nikolich, M. P., Belew, A. T., Fouts, D. E., McGann, P. T., Swierczewski, B. E., Getnet, D., Ellison, D. W., & Margulieux, K. R. (2022). Identification and Characterization of vB_PreP_EPr2, a Lytic Bacteriophage of Pan-Drug Resistant Providencia rettgeri. Viruses, 14(4), 708. https://doi.org/10.3390/v14040708








